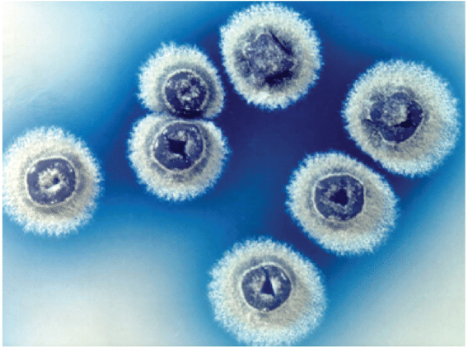

Parece ser que fue Aristóteles quien primero habló de los sentidos, su papel en el hombre y la clasificación de los mismos. Daba importancia a los sentidos en tanto que son la puerta abierta al mundo externo; para Aristóteles, la percepción (a través de los sentidos) es una forma de conocimiento.
Aristóteles llamó a los cinco sentidos “los sentidos esenciales”, y es que verdaderamente el tacto, el olfato, el oído, el gusto y la vista son la trama sensorial esencial que nos permite desenvolvernos en la vida, tanto desde un punto de vista meramente funcional como por su implicación en las emociones.
Si propusiéramos hacer el ejercicio de elegir personalmente uno de los sentidos, podríamos pensar, a priori, que en términos generales habría gran variabilidad a la hora de decidir las preferencias, pues cada persona se decantaría por aquel que en función del momento de la vida en que se encontrase o en función de su profesión, fuera el que más le aportara, el que mejor le defendiese o le calmase. Cabría pensar que la subjetividad de las muy diferentes situaciones daría lugar a respuestas muy diferentes.
Sin embargo, según los resultados obtenidos en un estudio realizado por el Instituto Max Planck, en el que los investigadores sirviéndose de conversaciones de hablantes de trece idiomas diferentes, analizaron la importancia que daban a los sentidos en función del número de veces que pronunciaban palabras relativas a cada uno de ellos, encontraron que el sentido al que más importancia se le da, independientemente de la cultura, es la vista, seguido del oído y el tacto, y siendo el sabor y el olor los menos relevantes.
Percepciones peculiares
En este artículo vamos a centrarnos en los denostados sentidos del olfato y el gusto, y tomando a estos como base de partida vamos a ver que los humanos nos mostramos peculiares en la percepción de ciertos olores y sabores.
La sensibilidad del sentido del olfato, tanto en términos cualitativos como cuantitativos, es muy diferente entre los distintos individuos. Así, la percepción de un olor como “agradable” varía mucho de unas personas a otras: de ahí la variedad de olores y perfumes con matices diferentes que se ofrecen en el mercado.
La capacidad para distinguir pequeñas variaciones de los distintos olores y diferencia de intensidades dentro de un mismo olor es también una cuestión individual, subjetiva: hay quien puede distinguir muy bien entre lo diferente; hay quien no.
Estas cuestiones de variaciones milimétricas no son baladíes. Son bien conocidos los catadores de vinos y aceites, muy valorados y demandados por sus exclusivas capacidades. En la industria alimentaria existen también los denominados de forma genérica “paneles de catadores”, integrados por personas con altas capacidades para distinguir diferencias organolépticas en los alimentos. Trabajan ciñéndose a normas (Aenor) con el fin de conseguir determinar posibles diferencias en las características sensoriales de un alimento, difíciles de detectar y caracterizar desde un punto de vista físico-químico y que pueden afectar significativamente a la aceptación del consumidor.
Olor a tierra mojada
A pesar de que tal como estamos presentado el tema, las cuestiones relativas al olor parecen ser de naturaleza muy subjetiva, hay un olor en particular, el olor a tierra mojada, a lluvia recién caída, en el que se da bastante consenso en cuanto a su aceptación.
Es posible que este olor sea uno de los que gozan de acuerdo general quizá porque se lo relacione con recuerdos plácidos, con sensaciones de relajación, de bienestar, de pureza, de limpieza; en definitiva, es un olor que, como decimos, tiende a ser aceptado y valorado como positivo por la mayoría de la población.
Sin embargo, ¡cómo somos los humanos!, aceptamos con placer el olor a tierra mojada y no toleramos que en el agua potable esté presente este mismo olor, es decir, esté presente el mismo compuesto químico responsable del mismo, aunque sea a una concentración tan baja como 10 nanogramos/litro). (1 ng son 10-9 gramos; o lo que es lo mismo, 1 gramo son 1000. 000. 000, mil millones de nanogramos).
El olor a tierra mojada y el olor en el agua son debidos a la presencia de varios compuestos químicos, comunes en ambos casos, siendo el principal de ellos la geosmina.
La geosmina, químicamente nombrada como 4,8a-dimetildecalina-4a-ol, pertenece estructuralmente al grupo de los naftalenos saturados (decalinas) y lleva unido además un grupo hidroxilo y dos metilaciones que forman un alcohol bicíclico volátil.
El hecho de que sea volátil hace que una parte importante de esta molécula, a una temperatura determinada, se encuentre en fase vapor, y por tanto accesible a los receptores del olor que poseemos los humanos.
¿Pero cómo son los protagonistas causantes de tanta controversia? Aunque como hemos dicho, hay varias moléculas responsables del olor a tierra mojada, los más importantes, porque aparecen con más frecuencia, son los denominados geosmina y metilisoborneol, que tienen estructuras tan pintorescas (para los profanos) como las que se muestran en la figura.
Aristóteles llamó a los cinco sentidos “los sentidos esenciales”, y es que verdaderamente el tacto, el olfato, el oído, el gusto y la vista son la trama sensorial esencial que nos permite desenvolvernos en la vida, tanto desde un punto de vista meramente funcional como por su implicación en las emociones.
Si propusiéramos hacer el ejercicio de elegir personalmente uno de los sentidos, podríamos pensar, a priori, que en términos generales habría gran variabilidad a la hora de decidir las preferencias, pues cada persona se decantaría por aquel que en función del momento de la vida en que se encontrase o en función de su profesión, fuera el que más le aportara, el que mejor le defendiese o le calmase. Cabría pensar que la subjetividad de las muy diferentes situaciones daría lugar a respuestas muy diferentes.
Sin embargo, según los resultados obtenidos en un estudio realizado por el Instituto Max Planck, en el que los investigadores sirviéndose de conversaciones de hablantes de trece idiomas diferentes, analizaron la importancia que daban a los sentidos en función del número de veces que pronunciaban palabras relativas a cada uno de ellos, encontraron que el sentido al que más importancia se le da, independientemente de la cultura, es la vista, seguido del oído y el tacto, y siendo el sabor y el olor los menos relevantes.
Percepciones peculiares
En este artículo vamos a centrarnos en los denostados sentidos del olfato y el gusto, y tomando a estos como base de partida vamos a ver que los humanos nos mostramos peculiares en la percepción de ciertos olores y sabores.
La sensibilidad del sentido del olfato, tanto en términos cualitativos como cuantitativos, es muy diferente entre los distintos individuos. Así, la percepción de un olor como “agradable” varía mucho de unas personas a otras: de ahí la variedad de olores y perfumes con matices diferentes que se ofrecen en el mercado.
La capacidad para distinguir pequeñas variaciones de los distintos olores y diferencia de intensidades dentro de un mismo olor es también una cuestión individual, subjetiva: hay quien puede distinguir muy bien entre lo diferente; hay quien no.
Estas cuestiones de variaciones milimétricas no son baladíes. Son bien conocidos los catadores de vinos y aceites, muy valorados y demandados por sus exclusivas capacidades. En la industria alimentaria existen también los denominados de forma genérica “paneles de catadores”, integrados por personas con altas capacidades para distinguir diferencias organolépticas en los alimentos. Trabajan ciñéndose a normas (Aenor) con el fin de conseguir determinar posibles diferencias en las características sensoriales de un alimento, difíciles de detectar y caracterizar desde un punto de vista físico-químico y que pueden afectar significativamente a la aceptación del consumidor.
Olor a tierra mojada
A pesar de que tal como estamos presentado el tema, las cuestiones relativas al olor parecen ser de naturaleza muy subjetiva, hay un olor en particular, el olor a tierra mojada, a lluvia recién caída, en el que se da bastante consenso en cuanto a su aceptación.
Es posible que este olor sea uno de los que gozan de acuerdo general quizá porque se lo relacione con recuerdos plácidos, con sensaciones de relajación, de bienestar, de pureza, de limpieza; en definitiva, es un olor que, como decimos, tiende a ser aceptado y valorado como positivo por la mayoría de la población.
Sin embargo, ¡cómo somos los humanos!, aceptamos con placer el olor a tierra mojada y no toleramos que en el agua potable esté presente este mismo olor, es decir, esté presente el mismo compuesto químico responsable del mismo, aunque sea a una concentración tan baja como 10 nanogramos/litro). (1 ng son 10-9 gramos; o lo que es lo mismo, 1 gramo son 1000. 000. 000, mil millones de nanogramos).
El olor a tierra mojada y el olor en el agua son debidos a la presencia de varios compuestos químicos, comunes en ambos casos, siendo el principal de ellos la geosmina.
La geosmina, químicamente nombrada como 4,8a-dimetildecalina-4a-ol, pertenece estructuralmente al grupo de los naftalenos saturados (decalinas) y lleva unido además un grupo hidroxilo y dos metilaciones que forman un alcohol bicíclico volátil.
El hecho de que sea volátil hace que una parte importante de esta molécula, a una temperatura determinada, se encuentre en fase vapor, y por tanto accesible a los receptores del olor que poseemos los humanos.
¿Pero cómo son los protagonistas causantes de tanta controversia? Aunque como hemos dicho, hay varias moléculas responsables del olor a tierra mojada, los más importantes, porque aparecen con más frecuencia, son los denominados geosmina y metilisoborneol, que tienen estructuras tan pintorescas (para los profanos) como las que se muestran en la figura.
El olor está en la materia, pero…
Presentamos estas estructuras para evidenciar que el “olor” está en la materia, en la fracción que cada uno de estos compuestos libera al aire cuando se evapora.
¿Cómo comprender que el mismo compuesto presente en la “tierra mojada” nos produzca bienestar y si está en agua de beber, rechazo?
Alguien no familiarizado con el tema diría que no es posible, que un “olor” es agradable –o no- independientemente de la matriz –tierra o agua- que lo soporta. Sin embargo, los responsables del suministro de agua potable bien saben cuántas quejas reciben por parte de los consumidores cuando la concentración, por ejemplo de la geosmina, sobrepasa un valor de 10 nanogramos/litro. Recordemos que hay personas que son capaces de detectar el olor a tierra mojada incluso cuando el compuesto responsable está a concentraciones tan bajas como 5 y 10 partes por trillón (ppt) (es decir, a 5 x 10-3 y 10-2 nanogramos/litro) .
De hecho, los gestores de las plantas de tratamiento deben invertir recursos técnicos y económicos importantes para eliminar la presencia de estos compuestos en el agua de potable que va a consumir la población.
¿De dónde vienen estos compuestos?; ¿por qué aparecen en el agua? Estos peculiares compuestos son producidos por microorganismos: bacterias, microalgas, fundamentalmente Actinomicetos y, dentro de este grupo, la especie Streotomyces coelicolor que es la más importante. En la figura 2 se muestra el aspecto de la misma.
Presentamos estas estructuras para evidenciar que el “olor” está en la materia, en la fracción que cada uno de estos compuestos libera al aire cuando se evapora.
¿Cómo comprender que el mismo compuesto presente en la “tierra mojada” nos produzca bienestar y si está en agua de beber, rechazo?
Alguien no familiarizado con el tema diría que no es posible, que un “olor” es agradable –o no- independientemente de la matriz –tierra o agua- que lo soporta. Sin embargo, los responsables del suministro de agua potable bien saben cuántas quejas reciben por parte de los consumidores cuando la concentración, por ejemplo de la geosmina, sobrepasa un valor de 10 nanogramos/litro. Recordemos que hay personas que son capaces de detectar el olor a tierra mojada incluso cuando el compuesto responsable está a concentraciones tan bajas como 5 y 10 partes por trillón (ppt) (es decir, a 5 x 10-3 y 10-2 nanogramos/litro) .
De hecho, los gestores de las plantas de tratamiento deben invertir recursos técnicos y económicos importantes para eliminar la presencia de estos compuestos en el agua de potable que va a consumir la población.
¿De dónde vienen estos compuestos?; ¿por qué aparecen en el agua? Estos peculiares compuestos son producidos por microorganismos: bacterias, microalgas, fundamentalmente Actinomicetos y, dentro de este grupo, la especie Streotomyces coelicolor que es la más importante. En la figura 2 se muestra el aspecto de la misma.

Figura 2: Streptomyces coelicor (En Research advances in understanding Streptomyces; K.F.Chater, 2016)
¿Bacterias, compuestos químicos, olores? ¿el olor de lo mismo en agua y tierra es diferente? ¿A qué nos lleva todo esto aparentemente tan confuso?
Cuestión de emociones
La explicación es quizá más sencilla: olemos lo que nos provocan nuestras emociones.
El olor a tierra mojada nos evoca una sensación de paz, de naturaleza serena; el olor del agua de beber, ¿qué provoca? ¿Qué esperamos del agua que bebemos? Del agua esperamos, de una manera inconsciente, que no tenga color, que no huela, y que no sepa. Un agua que huele nos hace desconfiar. Rechazamos aquello que no está en nuestras expectativas.
De modo que debemos concluir que la aceptación de algo está en función de lo que se espera. Adiós geosmina en el agua de beber, por muy entrañable que seas cuando te olemos en el campo tras un día de serena lluvia, rechazamos tu presencia cuando queremos calmar la sed, una necesidad más elemental, que situamos en el plano de lo necesario, por encima –lamentablememte- del placer, que colocamos en el plano de lo extraordinario.
(*) Camino García-Balboa y Paloma Martínez Alesón son investigadoras del Departamento de Producción Animal (Genética) de la Facultad de Veterinaria de la Universidad Complutense de Madrid. Beatriz Baselga Cervera es investigadora del Departamento de Ecología, Evolución y Comportamiento de la Universidad de Minnesota.
Cuestión de emociones
La explicación es quizá más sencilla: olemos lo que nos provocan nuestras emociones.
El olor a tierra mojada nos evoca una sensación de paz, de naturaleza serena; el olor del agua de beber, ¿qué provoca? ¿Qué esperamos del agua que bebemos? Del agua esperamos, de una manera inconsciente, que no tenga color, que no huela, y que no sepa. Un agua que huele nos hace desconfiar. Rechazamos aquello que no está en nuestras expectativas.
De modo que debemos concluir que la aceptación de algo está en función de lo que se espera. Adiós geosmina en el agua de beber, por muy entrañable que seas cuando te olemos en el campo tras un día de serena lluvia, rechazamos tu presencia cuando queremos calmar la sed, una necesidad más elemental, que situamos en el plano de lo necesario, por encima –lamentablememte- del placer, que colocamos en el plano de lo extraordinario.
(*) Camino García-Balboa y Paloma Martínez Alesón son investigadoras del Departamento de Producción Animal (Genética) de la Facultad de Veterinaria de la Universidad Complutense de Madrid. Beatriz Baselga Cervera es investigadora del Departamento de Ecología, Evolución y Comportamiento de la Universidad de Minnesota.
Referencia
Vision verbs dominate in conversation across cultures, but the ranking of non-visual verbs varies. Lila San Roque et al. Cognitive Linguistics, Volume 26, Issue 1, 2015-02-01. DOI: https://doi.org/10.1515/cog-2014-0089
Vision verbs dominate in conversation across cultures, but the ranking of non-visual verbs varies. Lila San Roque et al. Cognitive Linguistics, Volume 26, Issue 1, 2015-02-01. DOI: https://doi.org/10.1515/cog-2014-0089

 Tendencias Científicas
Tendencias Científicas

El coronavirus podría estar debilitándose
El coronavirus podría estar debilitándose CIENCIA ON LINE
CIENCIA ON LINE